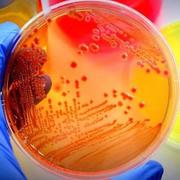
Microbiologia - EX1

Learn Microbiología
Study Microbiología using smart web & mobile flashcards created by top students, teachers, and professors. Prep for a quiz or learn for fun!
Brainscape Certified Flashcards (0)
Decks
Flashcards
Learners
User-Generated Flashcards (1,321)
Decks
Flashcards
Learners
-
Microbiologia
Microbiologia
By: Valeria Estefania Martinez Zapata
Caracteristicas Virus Y Bacterias, Virus, Corynebacterium- Borrelia...5Decks218Flashcards1Learner -
Microbiología
Microbiología
By: Ivan Mendo
Micro 11Decks44Flashcards4Learners -
Microbiologia De alimentos
Microbiologia De alimentos
By: Elia Tristancho
Infecciones Por Alimentos, Echerichia Coli, Shiguella...7Decks72Flashcards1Learner -
Microbiologia
Microbiologia
By: Carol Alves
Primeira Parcial1Decks20Flashcards1Learner -
Microbiologia
Microbiologia
By: Alice Gomes
Bacteriologia, Fungos2Decks17Flashcards1Learner -
Microbiología
Microbiología
By: A A
Infecciosas1Decks92Flashcards2Learners -
Microbiologia
Microbiologia
By: Eduardo Bach Pinheiro
Nutrição de bactérias.xlsx, Agentes-químicos, Meios-de-Culrura-de-Bactérias...7Decks144Flashcards1Learner -
Microbiologia
Microbiologia
By: Kawanny Costa
Microbiologia, Prova 2 bactérias2Decks179Flashcards1Learner -
Microbiologia Infeções
Microbiologia Infeções
By: Rita Duarte
infeção hospitalar, crescimento bacteriano, Gram Negativas3Decks79Flashcards1Learner -
Microbiología
Microbiología
By: Maria Flores Diaz
Bacteriología1Decks34Flashcards2Learners -
MICROBIOLOGIA

MICROBIOLOGIA
By: ARTHUR ALVES
Fungos, Bactérias, Bactérias II...4Decks161Flashcards1Learner -
Microbiologia - EX1
Microbiologia - EX1
By: Gisliel Santos
Classificação Reinos e Simbiose, Transmissão, Incubação - Vírus - Gerais...6Decks202Flashcards1Learner -
Microbiología
Microbiología
By: Camila J
Parcial 11Decks43Flashcards3Learners -
Biologia
Biologia
By: Esther Lanzoni
Introdução, Bioquímica, Biologia molecular e engenharia genética...18Decks132Flashcards1Learner -
MICROBIOLOGIA
MICROBIOLOGIA
By: Leticia Da Fonte
CARACTERISTICAS PRO E EUC, MORFOLOGIA BAC COCOS, MORFOLOGIA BACILOS...8Decks38Flashcards1Learner -
Temas Selectos de Biología
Temas Selectos de Biología
By: Carolina Ledesma
Ciencia, Método Científico, Historia de la Microbiología...4Decks38Flashcards4Learners -
Microbiologia
Microbiologia
By: Karma Akabane
Gram-positivi, Micobatteri e Micoplasmi, Gram Negativi...4Decks105Flashcards1Learner -
MICROBIOLOGÍA

MICROBIOLOGÍA
By: Alejandro Aguilar Pérez
GENERALIDADES (1°P), BACTERIOLOGÍA (1°P)2Decks125Flashcards2Learners -
Concurso Embrapa
Concurso Embrapa
By: Ashley Uchoa
Microbiologia, Insumos Biológicos, Português...5Decks42Flashcards2Learners -
Microbiologia
Microbiologia
By: Karla Teixeira
Micobacterias-Tuberculose, Clostriidium Tetani, Intoxicacao Alimentar3Decks45Flashcards2Learners -
Bacteriología
Bacteriología
By: Maria Eduarda Bettanin Maria E
Introducción a la microbiología, Bacteriología generalidades, Cocos gram positivo...4Decks114Flashcards1Learner -
Microbiologia Oral - cárie II

Microbiologia Oral - cárie II
By: Gabriella Dias
Microbiota Oral, Introdução a biofilmes dentários, Formação dos biofilmes dentários...5Decks53Flashcards2Learners -
MICROBIOLOGÍA
MICROBIOLOGÍA
By: Perla Gamboa
VRUS RESPIRATORIO, VIRUS DIGESTIVO, VIRUS ENF EXANTEMÁTICAS...6Decks21Flashcards4Learners -
Microbiologia
Microbiologia
By: Jeferson Dos S. Matos
Bacillus Gram Negativos, Bacillus Gram positivos, Gram Negativos Curvos...11Decks78Flashcards2Learners -
Microbiología
Microbiología
By: Ariadna Perea
Crecimiento Y Muerte Bacteriana, Streptococcus Y Stafilococcus, Rickettsias Y Virus...4Decks85Flashcards2Learners -
Microbiología
Microbiología
By: José Gerardo Aguilar Davalos
Bacterias Estructura, Terapeutica Antimicrobiana2Decks128Flashcards2Learners -
Microbiología P1
Microbiología P1
By: Clara Castañeda
Taxonomía, Morfología y estructura Bacteriana, Mecanismos de tranferencia genética...7Decks81Flashcards2Learners -
Biologia

Biologia
By: Beatriz França
Citologia, Genética, Compostos orgânicos...8Decks83Flashcards2Learners -
MICROBIOLOGÍA
MICROBIOLOGÍA
By: ARLETH MICHELLE TERAN SANTOS
1er parcial1Decks50Flashcards2Learners -
Microbiología II
Microbiología II
By: Lisette Bruijnzeels
Antiparasitarios, Parasitosis intestinal2Decks172Flashcards2Learners


